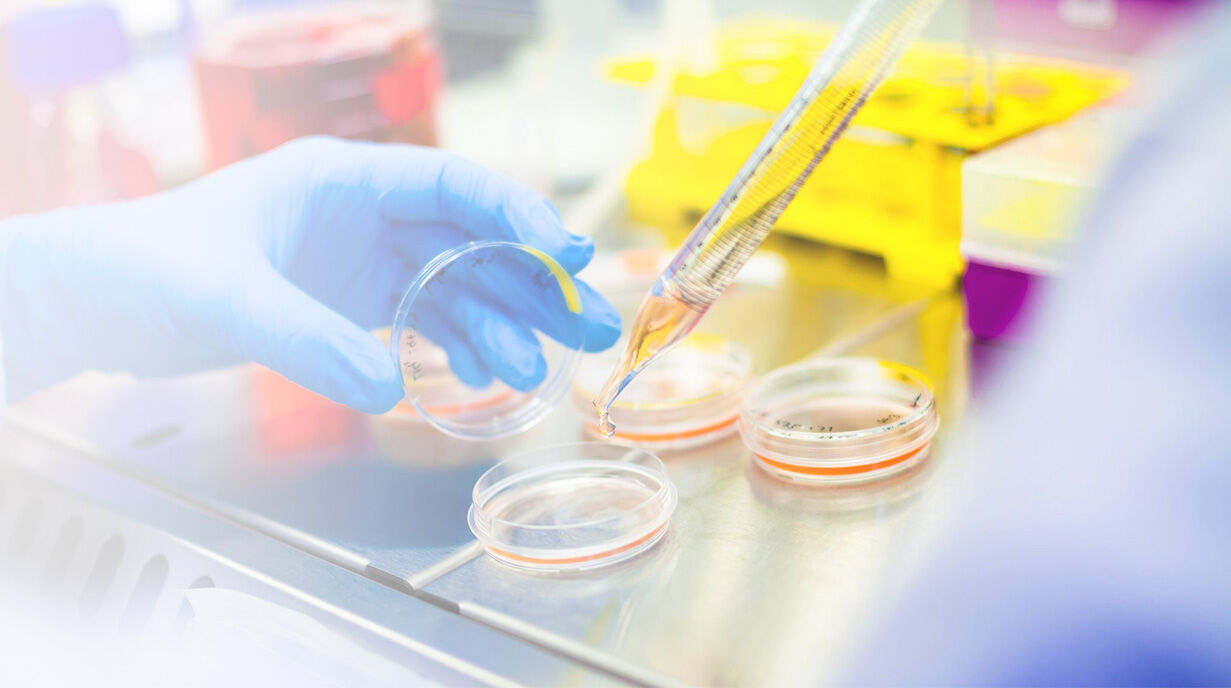

ABOUT US
GP Natural Products Co., Ltd. is located in Linzi District,Zibo City,Shandong Province,with a registered capital of RMB 30million ($4.5 million ).Our main products are functional specialty monomers and natural guar gum-based additives. We believe that the scientific and technological innovations drive the company growth. That’s why we put great emphasis on Research and Development and Product Innovation. We have built the state of the art R&D facility and analytical testing center.We have ten Patents which are approved as National Invention Patents.

EXPLORE OUR MAIN SERVICES
WE ADVICE TO CHOOSE
A RIGHT DECISION
1. Continuous production of 2.3-dimethyl-1-buteneby 2.3-dmethyl-2-butene
2. Catalytic synthesis of n-butyl hydroxy acetate
3. Preparation of carboxymethyl hydroxyalkyl guargum powder by one-step etherification
4. Preparation of camphene by alpha pinene
5. Preparation of cationic guar powder with low viscosity
Read More
1. National high-tech enterprise
2. Industry leading talents in TaishanShandong Province
3. The third Shandong Provinceentrepreneurship competition second prize
4. The top twenty innovative high growthenterprises in Linzi District
5. Shandong engineering technology center
WE’LL ENSURE YOU ALWAYS GET
BEST RESULTS.

17
Fine Chemical Production Experience
5
Key Experiments

80
R & D Personnel

12
Project Invention Patent
COMPANY EVENT
Inquiry For Pricelist
Since its establishment, our factory has been developing first world class products with adhering the principle of quality first. Our products have gained excellent reputation in the industry and valuabletrusty among new and old customers..
LATEST NEWS & BLOGS



Leave Your Message